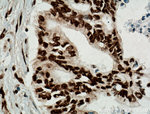
TDP-43 Antibody in Immunohistochemistry (Paraffin) (IHC (P))

Search
Proteintech
TDP-43 Monoclonal Antibody (6H6E12)
{{$productOrderCtrl.translations['antibody.pdp.commerceCard.promotion.promotions']}}
{{$productOrderCtrl.translations['antibody.pdp.commerceCard.promotion.viewpromo']}}
{{$productOrderCtrl.translations['antibody.pdp.commerceCard.promotion.promocode']}}: {{promo.promoCode}} {{promo.promoTitle}} {{promo.promoDescription}}. {{$productOrderCtrl.translations['antibody.pdp.commerceCard.promotion.learnmore']}}
产品信息
60019-2-IG
种属反应
已发表种属
宿主/亚型
分类
类型
克隆号
抗原
偶联物
形式
浓度
规格
纯化类型
保存液
内含物
保存条件
运输条件
产品详细信息
60019-2-Ig is a mouse monoclonal antibody recognizing the cleavage product of 20-30 kDa in addition to the native and phosphorylated forms of TDP-43. Immunohistochemical analyses of TDP-43 using this antibody detect both normal diffuse nuclear staining and insoluble inclusions in pathologic tissues. Notably this antibody only recognizes human TDP-43 but not reacts with mouse or rat TDP-43.
靶标信息
TDP43 was first identified as a novel cellular protein that binds to HIV-1 virus TAR DNA sequence motifs and acts a transcriptional repressor to the HIV-1 LTR. Later experiments revealed that TDP43 also regulates the splicing of exon 9 of the cystic fibrosis transmembrane conductance regular (CFTR), most likely through the association with the UG repeats at the 3"e; splice site. A hyperphosphorylated, ubiquitinated, and cleaved form of TDP43 known as pathologic TDP43 is the major disease protein in ubiquitin-positive, tau-, and alpha-synuclein-negative frontotemporal dementia (FLTD-U). TDP43 is not related to TRBP1, and RNA binding protein that binds HIV-1 TAR RNA sequences.
仅用于科研。不用于诊断过程。未经明确授权不得转售。
生物信息学
蛋白别名: OTTHUMP00000002171; OTTHUMP00000002173; RP4-635E18.2; TAR DNA-binding protein 43; TAR DNA-binding protein-43; TARDBP; TDP-43; unnamed protein product
基因别名: ALS10; TARDBP; TDP-43; TDP43
UniProt ID: (Human) Q13148
Entrez Gene ID: (Human) 23435